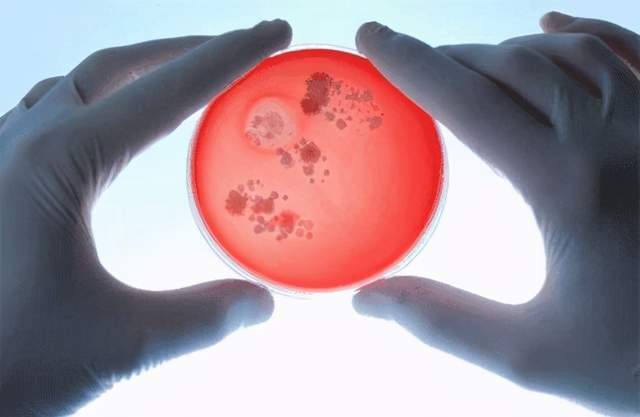
国内最新研究:揭示了粪菌移植对自闭症的影响

粪菌

希望or骗局?"粪菌移植治疗自闭症"屡上热搜的内幕
图片尺寸966x635
粑粑能治病粪菌移植作用多
图片尺寸640x561
粪菌移植,预测免疫疗法,这家肠道微生态治疗公司获新融资
图片尺寸640x480
粪菌移植有望保护接受抗生素治疗的新生儿
图片尺寸900x559
自闭症儿童粪菌移植改善大吗
图片尺寸800x600
粪菌移植的不仅是菌,连焦虑都跟着移植了?
图片尺寸600x372
粪菌移植太粗放精准调菌有5招
图片尺寸1280x852
聚焦亚洲人群,开发个体化疗法,东南亚首家粪菌库成立!
图片尺寸1080x718
粪菌移植是医学新的治疗技术可以治疗炎症性肠病便秘肠易激综合征艰难
图片尺寸1139x710
二代粪菌移植:超级粪便要来了?
图片尺寸620x372
热心肠先生:50图 10000字,超深度解读粪菌移植!
图片尺寸640x513
热心肠先生:50图 10000字,超深度解读粪菌移植!
图片尺寸640x427
"粪菌移植"可显著缓解癌症免疫治疗并发症,仅2个病例便登上nature
图片尺寸1800x720
捐屎|赚钱|粪便|疾病|粪菌|-健康界
图片尺寸800x533
大便治病"并非不存在,医疗上利用"粪菌移植"以治疗人体疾病的医疗方式
图片尺寸555x364
应该也是受到《肘后备急方》的启发,这也意味着,粪菌的功能性作用,从
图片尺寸554x360
备受关注的粪菌移植被fda警告并计划叫停临床试验
图片尺寸1800x720
国内最新研究:揭示了粪菌移植对自闭症的影响
图片尺寸640x417
现在开始尝试一种"吃屎"疗法 从健康人的粪便中提取粪菌 再植入到
图片尺寸587x415
本文作者 tadpole |公众号 biokiwi 本文关键词 溃疡性结肠炎粪菌
图片尺寸500x281